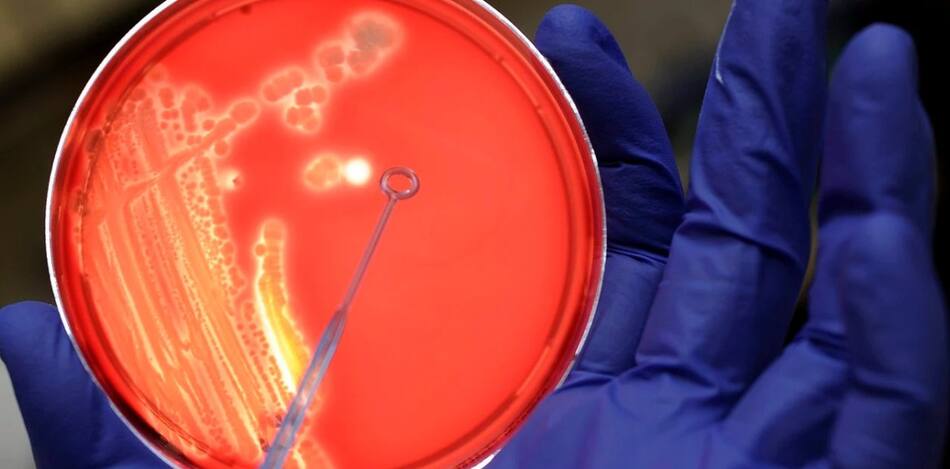

Aumento de casos de Síndrome Urémico Hemolítico: síntomas y cómo prevenirlo

El síndrome urémico hemolítico volvió a alertar a los especialistas luego de que la curva, que fue descendente en los últimos años, volviera a crecer con más casos en 2023 que en 2021 y 2022. Según el último Boletín Epidemiológico Nacional se registró un "ligero aumento" de los casos en las primeras 23 semanas del 2023 respecto a los dos años anteriores, con un total de 159 casos, de los cuales 126 son menores de 5 años.
"El SUH es una enfermedad caracterizada por la destrucción de glóbulos rojos (anemia hemolítica) y la disminución de las plaquetas en la sangre (trombocitopenia) con compromiso de múltiples órganos, en especial los riñones, lo que puede llevar a insuficiencia renal aguda", indicó Diego Ripeau, médico del Departamento de Pediatría del Hospital de Clínicas.
"La causa más común de SUH está asociada con infecciones intestinales causadas por la bacteria Escherichia coli productora de toxina Shiga (STEC)", agregó el profesional a través de un comunicado del hospital dependiente de la Universidad de Buenos Aires (UBA), y precisó que la enfermedad se desencadena por la ingestión de alimentos o agua contaminados con la bacteria.
Bacterias en análisis de la Escherichia coli. Foto: EFE
También podría interesarte
Durante la pandemia se había registró un leve descenso de las notificaciones, con un promedio de 24 casos en 2020, 22 en 2021 y 24 en 2022. Sin embargo en 2023, ese número comenzó a crecer y en lo que va del año se registraron 122 casos de internación, 57 de ellos en cuidados intensivos, 27 requirieron de diálisis peritoneal, 20 transfusiones y hubo 3 muertes.
Si bien el SUH afecta a 3,4 niños sobre 100.000, el 77% del total de los casos requieren internación. En tanto, el médico pediatra advirtió que esta afección "es la segunda causa de insuficiencia renal crónica en niños y de trasplantes renales en edades pediátricas, pese a ser una enfermedad prevenible".
¿Qué hacer para prevenir esta enfermedad?
Las recomendaciones que emitió hoy el Hospital de Clínicas para prevenir el síndrome urémico hemolítico, una enfermedad que es la segunda causa de trasplante renal en niñas y niños, son:
- Lavarse cuidadosamente las manos después de ir al baño y antes de preparar alimentos
- Cocinar adecuadamente la carne
- Evitar comer carne poco cocida.
- Para cortar alimentos no usar el mismo cuchillo o superficie (tablas, mesadas) que se usa para carnes crudas, sin antes lavarlo bien con agua y detergente.
- Consumir leche y productos lácteos pasteurizados
- Lavar bien frutas y verduras antes de consumirlas.

Consumir leche y productos lácteos pasteurizados es una de las recomendaciones para prevenir el SUH. Foto UNSPLASH.
¿Cuáles son sus síntomas?
Entre los síntomas para estar alerta, el médico indicó que el síndrome se desarrolla por etapas: "primero, al llegar la bacteria al intestino, produce diarrea intensa, en la mayoría de los casos con sangre, vómitos, dolor abdominal y decaimiento".
"A los pocos días, es seguido por un cuadro de palidez, debilidad, sensación de fatiga, manchas rojas en la piel y hematomas. En casos más graves, el SUH puede generar convulsiones, daño neurológico e incluso la muerte", completó el profesional.

Pueden pasar más de 3 días desde el momento en que la bacteria Escherichia coli infecta al organismo y se desarrollen los síntomas de síndrome urémico hemolítico. Foto Unsplash.
Y concluyó: "Es importante acudir de inmediato al médico ante cualquier sospecha de SUH, ya que el tratamiento temprano mejora las posibilidades de recuperación".



















